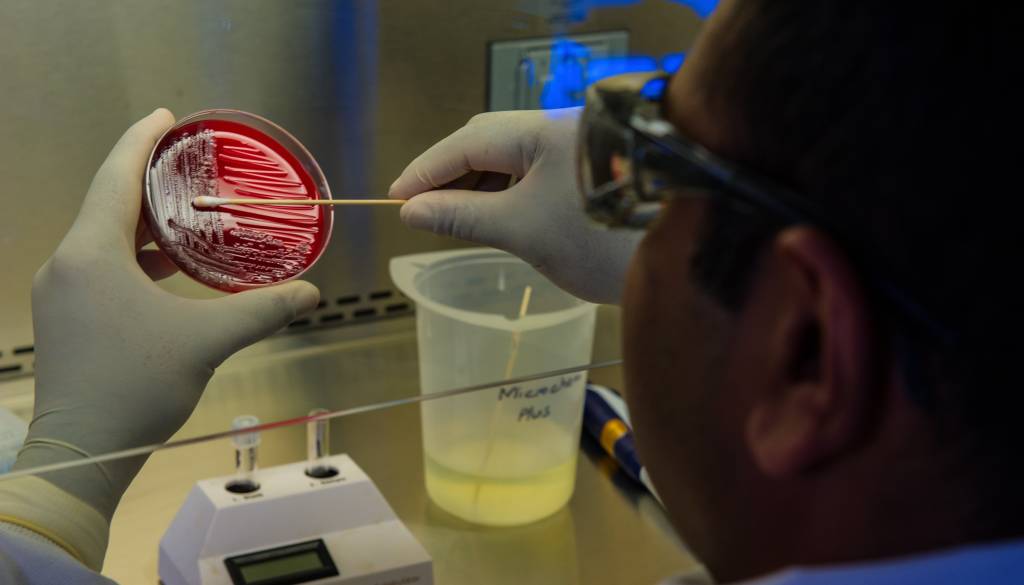

Raziskovalci Nacionalnega inštituta za biologijo so ob priljubljeni sprehajalni poti v Ljubljani ob potoku Glinščica zaznali potencialno strupene cianobakterije.
Kot je Nacionalni inštitut za biologijo objavil na svoji spletni strani, so pred kratkim dobili klic domačina, ki ga je skrbelo za zdravje njegovega psa, ki redno čofota po potoku Glinščica ob Poti spominov in tovarištva na Brdu. Tam je bila namreč prisotna gošča na vodni površini, ki se je vidno penila.
Inštitut je še isti dan preveril stanje in pod mikroskopom prepoznal veliko količino cianobakterij, nato pa preveril še njihov genetski zapis. Izkazalo se je, da nosijo gene za proizvodnjo cianotoksinov, kar pomeni, da so lahko strupene.
»Če so v tistem trenutku proizvajale toksine, še ni znano, bodo pa na to odgovorile nadaljnje analize,« so zapisali na Inštitutu.
Znaki zastrupitve
Ta vrsta toksinov (anatoksini) sicer deluje na živčni sistem, značilni znaki zastrupitve so predvsem mišični krči ali paraliza nog, drgetanje, penjenje okrog ust, bruhanje in težave z dihanjem.
Navadno se pokažejo zelo kmalu po zastrupitvi, lahko takoj po stiku z vodo ali pa do nekaj ur kasneje.
Običajne okoljske koncentracije cianotoksinov so za ljudi ob kratkoročni izpostavljenosti večinoma neškodljive, ob dolgoročni izpostavljenosti pa obstajajo tveganja, je zapisano na spletni strani Ciano SLO.
Na tej lokaciji prvič zaznali prisotnost bakterije
Na tej lokaciji ob priljubljeni sprehajalni poti v Ljubljani strupenih cianobakterij doslej še nikoli niso zaznali. Na Inštitutu sicer pravijo, da se lahko stanje hitro spreminja, predvsem ob nevihtah, ki so napovedane v teh poletnih dne.